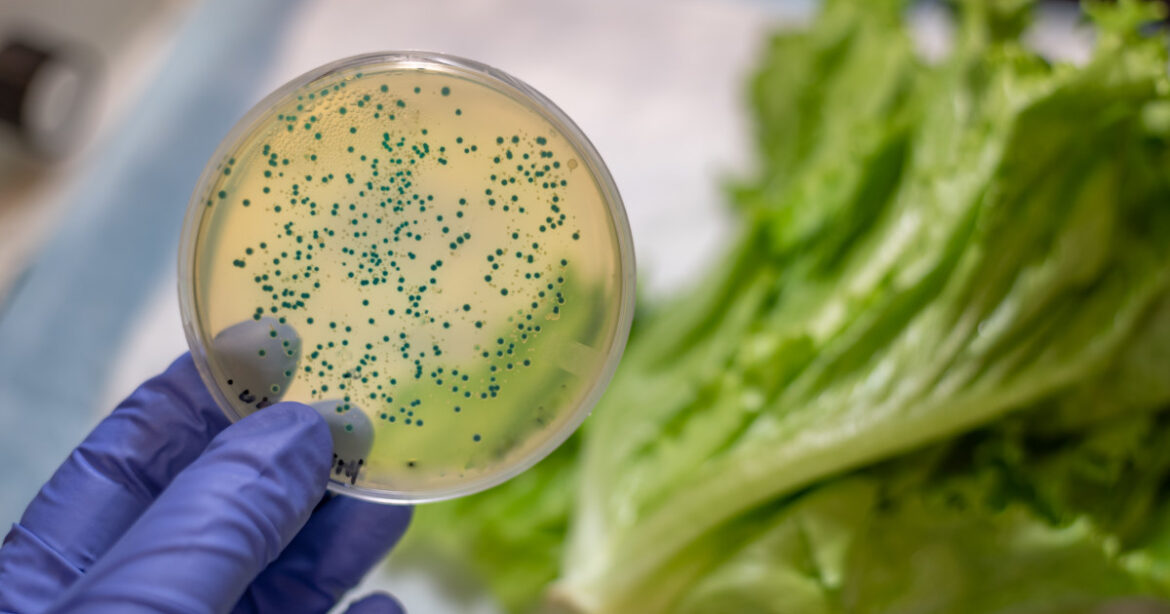
Petrischale im Labor

Forschende an der ETH Zürich haben Bakterien so herangezüchtet, dass sie Chemikalien für Plastik, Farbstoffe und künstliche Aromen herstellen können. Zukünftig könnten diese Bakterien Erdöl mit einem CO2-negativen Herstellungsprozess ablösen.
Fossile Energieträger wie Erdöl sind für die Herstellung von chemischen Produkten und Alltagsgegenständen wie PET-Flaschen, Jacken aus Polyester und Ladekabel aus Nylon nicht wegzudenken – doch vielleicht wird sich das bald ändern. Aktuell verbraucht die chemische Industrie mehr als eine Million Tonnen Erdöl, Erdgas und Kohle und benötigt dazu sehr viel Energie. Daraus folgt, dass der Anteil der chemischen Industrie allein ungefähr fünf Prozent des weltweiten CO2-Ausstosses ausmacht. Um diesen Wirtschaftszweig möglichst umweltschonend zu machen, sucht die Forschung stets nach Möglichkeiten, die chemische Industrie weniger abhängig von fossilen Rohstoffen zu machen.
Ein Weg setzt bei Bakterien an, die sich vom Alkohol Methanol ernähren. Die Synthese, also die Herstellung von Methanol, ist relativ einfach, da dafür lediglich zwei Zutaten benötigt werden: Kohlendioxid und Wasser. Kommt die Energie für diesen Prozess aus erneuerbaren Quellen, gilt das Methanol als grün und somit als umweltfreundliche Alternative zu fossilen Energieträgern.

Um den Verbrauch von Erdöl zu senken, können in Zukunft nachhaltigere Prozesse für die Herstellung von zahlreichen Chemikalien verwendet werden. Bild: jazavac / Depositphotos
Obwohl es auch natürliche methylotrophe Bakterien gibt, lassen sich diese bis jetzt kaum industriell verwenden, unter anderem weil das biologische Wissen über sie noch relativ gering ausfällt. Nun hat ein Forschungsteam an der ETH Zürich jedoch einen Weg gefunden, das relativ einfache Modellbakterium Escherichia coli dazu zu bringen, Methanol biotechnologisch zu verwerten. Unter der Leitung von Professorin Julia Vorholt verfolgt ein Team um Postdoktorand Michael Reiter und Doktorand Timothy Bradley bereits seit Jahren dieses Forschungsziel.
Auf Zucker gewachsen
Das Bakterium Escherichia coli – kurz E. coli genannt – ist in der Biotechnologie beliebt, da es unkompliziert auf Zucker wachsen kann und eine hohe Wachstumsrate hat. Entsprechend lässt sich das Bakterium schnell anpassen und verändern. E. coli ist in geringen Mengen auch im menschlichen Darm natürlich anzutreffen, wo es zur Bildung von B-Vitaminen sowie zur Zerlegung von Proteinen und Kohlenhydraten beiträgt. Damit es im Labor Methanol biochemisch verändern kann, muss sein Stoffwechsel jedoch gänzlich umstrukturiert werden.
Als Grundlage für den Zuchtprozess wurde die Umstellung des Stoffwechsels als erstes anhand von Computermodellen getestet. Anschliessend wurden auch im Labor zwei Gene vom E. coli entfernt und dafür drei neue Gene eingeschleust. Durch diese Veränderung haben die Bakterien, welche zu den Mikroben zählen, die Fähigkeit erlangt, Methanol aufzunehmen. Jedoch konnten sie das vorerst lediglich in geringen Mengen. Nach einem weiteren Zuchtprozess, der ein Jahr dauerte, war die Umstellung vollbracht und die Mikroben konnten alle Zellbestandteile aus Methanol herstellen. «Nach etwa 1000 zusätzlichen Generationen wurden die künstlich geschaffenen Methylotrophen stetig effizienter, sodass sich ihre Anzahl schliesslich zu jeder vierten Stunde verdoppelte, wenn ihnen Methanol geliefert wurde», sagt Michael Reiter.

Der Biologe Michael Reiter sieht in der Herstellung von klimaneutralen Chemikalien in vielerlei Hinsicht eine grosse Chance. Bild: zVg
Für diese erhöhte Effizienz der Methanolverwertung sind zugleich mehrere Mutationen verantwortlich, die zufällig durch die Zucht entstanden sind. Die meisten Mutationen haben dafür gesorgt, dass verschiedene Gene des Bakteriums ihre Funktion verloren haben, um an Energie zu sparen. Auf diese Weise werden unnötige Kreisläufe vermieden und der restliche Stoffwechsel in den Zellen optimiert.
Schneller, effizienter, CO2-negativ
Das Forschungsteam hat sich zum Ziel gesetzt, die Methylotrophen möglichst effizient für die Verwendung in der chemischen Industrie zu konstruieren. Dafür hat es die Bakterien mit zusätzlichen Genen für vier unterschiedliche Wege der Biosynthese vorbereitet – ein Erfolg, wie sich im Labor herausstellte. Die Bakterien konnten in allen untersuchten Fällen die gewünschten Verbindungen herstellen. Dieses Ergebnis bedeutet für die Forschenden einen eindeutigen Beleg, dass die gezüchteten Bakterien ihren Zweck erfüllen. Die entwickelten Mikroben stellen also eine Art von Produktionsplattform dar, in die sich verschiedene Biosynthesemodule einbauen lassen. Je nachdem, in welche Substanz die Bakterien Methanol umwandeln sollen.
Bevor sie jedoch wirtschaftlich genutzt werden können, müssen die Mikroben noch weiterentwickelt werden. «Einerseits soll der Stamm der Mikroben genetisch noch leistungsfähiger werden, zum anderen soll der Prozess auch mit grossen Mengen ermöglicht werden, um auf dem Markt konkurrenzfähig zu sein», sagt Michael Reiter. Das Team hat bereits Innovationsfördermittel erhalten, um weitere Modelle zu entwickeln, wie die Mikroben verwendet werden können und auf welche chemischen Produkte der Anwendungsfokus zuerst gelegt werden soll. «Wir sind inzwischen schon dabei, erste Schritte in Richtung Vermarktung in Form eines Start-ups zu machen», so der Biologe.

In einem solchen Reaktor lassen die Forscher das modifizierte E. coli Methanol umwandeln. Bild: zVg
Der Fund des Forschungsteams könnte eine grosse Rolle spielen, denn eine Alternative zu fossilen Rohstoffen würde einen grossen Schritt zur Verlangsamung der Klimaerwärmung bedeuten. Eine Technologie, die nicht nur keinen Kohlenstoffdioxid produziert, sondern durch die Verwertung von Methanol sogar CO2-negativ ist, bringt grosse Hoffnung mit sich. Wenn der Plan der Forschenden aufgeht, werden die gezüchteten Bakterien in der nahen Zukunft in grösseren Mengen erneuerbare Chemikalien herstellen können.
Forschungsfeld mit Zukunft
Durch das neue Bakterium könnte auch das ganze Forschungsfeld profitieren: «Unser Erfolg würde eine gewisse Strahlkraft haben und mehr Forschende auf dieses Gebiet sowie auf die Forschung im Bereich der Nachhaltigkeit aufmerksam machen», sagt Timothy Bradley. Dies sieht Michael Reiter genauso und ergänzt: «Eine solche Industrie, wie wir sie in Zukunft sehen wollen, braucht ausgebildete und erfahrene Fachkräfte aus verschiedenen Sparten der Wissenschaft, denn es werden zahlreiche Probleme und Fragen aus unterschiedlichen Teilgebieten auftauchen.»

Doktorand Timothy Bradley arbeitet nun daran, die Produktion von CO2-negativen Chemikalien in grossen Mengen zu ermöglichen. Bild: zVg
«Mit unserer Technologie soll eine ökonomische Herstellung von klimaneutralen Chemikalien in Zukunft möglich sein», sagt Reiter. Die ersten Berechnungen und technologischen Modelle zeigen, dass sich in fünf bis zehn Jahren Prozesse für die Massenproduktion etabliert haben sollten, die mit der herkömmlichen Industrie konkurrieren können.